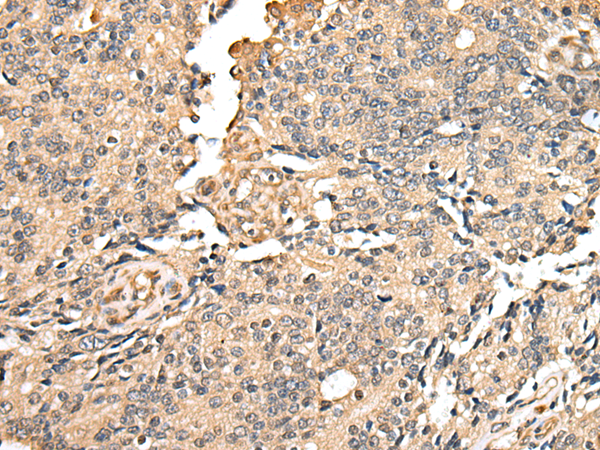
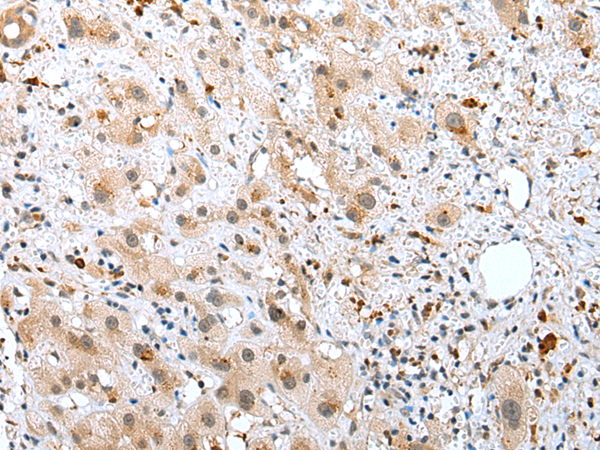
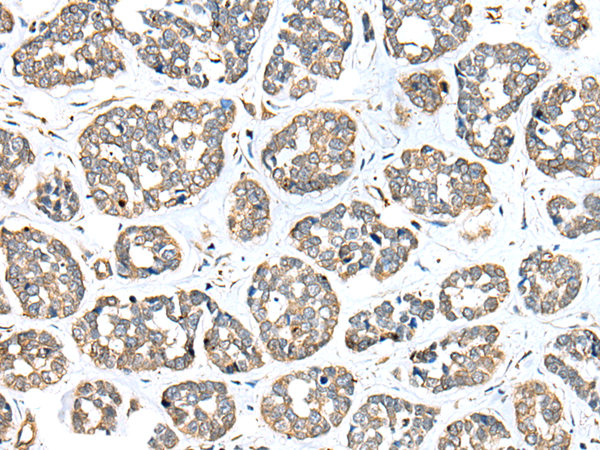

-
分类: 科研抗体货号: P09148别名: SECP43; PRO1902; TRSPAP1应用: IHC反应种属: Human, Mouse, Rat
-
分类: 科研抗体货号: P09125别名: SS2; BTN7; BTL-II; HSBLMHC1应用: WB,IHC反应种属: Human, Mouse
-
分类: 科研抗体货号: P09166别名: SBDN; TRS23; PTD009; CGI-104; HSPC172; SYNBINDIN应用: WB,IHC反应种属: Human, Mouse, Rat
-
分类: 科研抗体货号: P09147别名:应用: IHC反应种属: Human
-
分类: 科研抗体货号: P09124别名:应用: IHC反应种属: Human, Mouse
-
分类: 科研抗体货号: P09165别名: GTM4; GSTM4-4应用: WB,IHC反应种属: Human, Mouse
-
分类: 科研抗体货号: P09146别名: P18; AIMP3应用: WB,IHC反应种属: Human, Mouse
-
分类: 科研抗体货号: P09123别名: CHP; ARHV; WRCH2应用: IHC反应种属: Human, Mouse, Rat
-
分类: 科研抗体货号: P09164别名: ARG1; LCN7; LIECG3; TINAGRP应用: WB,IHC反应种属: Human, Mouse, Rat
-
分类: 科研抗体货号: P09145别名: DHP; DPD; DHPDHASE应用: IHC反应种属: Human, Mouse, Rat

鄂公网安备42018502007531号
鄂公网安备42018502007531号

